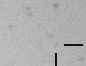
nm314_i.gif

Extragalactic Novae - 2003
This data comes from IAU Circulars and occasionally more data will be provided on IAU's Astronomical Headlines page. An archive of the 2003 updates to this page is available.
Due to the large number of Extragalactic Novae announced in 2003 I have decided to give these novae their own archive, so that you don't need to hunt through the main 2003 supernova archive to find them. Sometimes these novae go unreported to CBAT. If you know of any, please e-mail me and I will include them here. On these pages, I only report extragalactic events. I draw the line at NGC 2419. Anything closer is a "galactic event". The names for these novae are durived from the CBAT naming convention for novae in the SMC and LMC. Note that I assigned these names, not CBAT. The CBAT convention for referring to them is "nova xxx in IAUC yyyy", which is difficult to use if a nova does not appear in an IAUC.
This is a list of the Extragalactic Novae discovered in 2003. Current Novae can be found on the main page.

|
Nova M81 2003 7,
Unannounced
discovered 2003/05/09.883 by
K. Hornoch
|

|
Nova M81 2003 6,
Unannounced
discovered 2003/05/09.883 by
K. Hornoch
|

|
Nova M81 2003 5,
Unannounced
discovered 2003/05/21.932 by
K. Hornoch
|

|
Nova M81 2003 4,
Unannounced
discovered 2003/09/18.382 by
K. Hornoch
|

|
Nova M81 2003 3,
Unannounced
discovered 2003/09/18.382 by
K. Hornoch
|

|
Nova M81 2003 2,
Unannounced
discovered 2003/09/18.382 by
K. Hornoch
|

|
Nova M31 2003 18,
IAUC 8262
discovered 2003/12/20.708 by
Observatory G. Colombo
|

|
Nova M31 2003 17,
IAUC 8262
discovered 2003/12/20.708 by
Observatory G. Colombo
|

|
Nova M31 2003 16,
IAUC 8262
discovered 2003/12/19.696 by
Martin Mobberley
|

|
Nova M31 2003 15,
IAUC 8253
discovered 2003/12/03.772 by
Observatory G. Colombo
|

|
Nova M31 2003 14,
IAUC 8248
discovered 2003/11/09.073 by
Kamil Hornoch;
Observatory G. Colombo
|

|
Nova M31 2003 13,
IAUC 8238
discovered 2003/10/25.942 by
Observatory G. Colombo
|

|
Nova M31 2003 12,
IAUC 8226
discovered 2003/10/15.865 by
Observatory G. Colombo;
Kamil Hornoch and Peter Kusnirak
|

|
Nova M31 2003 11,
IAUC 8222
discovered 2003/10/06.908 by
Observatory G. Colombo
|

|
Nova M31 2003 10,
IAUC 8222
discovered 2003/09/30.835 by
Kamil Hornoch
|

|
Nova M31 2003 9,
IAUC 8210
discovered 2003/08/31.78 by
T. A. Rector
|

|
Nova M31 2003 8,
IAUC 8205
discovered 2003/09/17.16 by
Tom Boles
|

|
Nova M33 2003,
IAUC 8195
discovered 2003/09/01.4 by
LOTOSS
|
|
Nova M31 2003 7,
IAUC 8165
discovered 2003/07/19.031 by
Astronomical Observatory G. Colombo
|
|
Nova M31 2003 6,
IAUC 8165
discovered 2003/07/19.986 by
Kamil Hornoch;
Astronomical Observatory G. Colombo
|

|
Nova M31 2003 5,
IAUC 8165
discovered 2003/07/14.99 by
Kamil Hornoch
|
|
Nova M31 2003 4,
IAUC 8157
discovered 2003/06/21.021 by
Kamil Hornoch
|

|
Nova M31 2003 3,
IAUC 8155
discovered 2003/06/19.034 by
Astronomical Observatory G. Colombo
|

|
Nova M31 2003 2,
IAUC 8155
discovered 2003/06/19.034 by
Astronomical Observatory G. Colombo
|

|
Variable near UGC 10700,
IAUC 8153
discovered 2003/06/17.4 by
LOTOSS
|

|
Variable near NGC 6822,
IAUC 8141
discovered 2003/03/28.4 by
LOTOSS
|

|
Nova M81 2003,
IAUC 8069
discovered 2003/02/09.4 by
LOTOSS
|

|
Nova M31 2003,
IAUC 8052
discovered 2003/01/08.1 by
LOTOSS;
Padua group
|

|
Nova NGC 185 2003,
IAUC 8047
discovered 2003/01/05.1 by
LOTOSS
|
Back to Bright Supernovae.
Back to Supernova Archives.
Please send feedback to David Bishop dbishop@vhdl.org